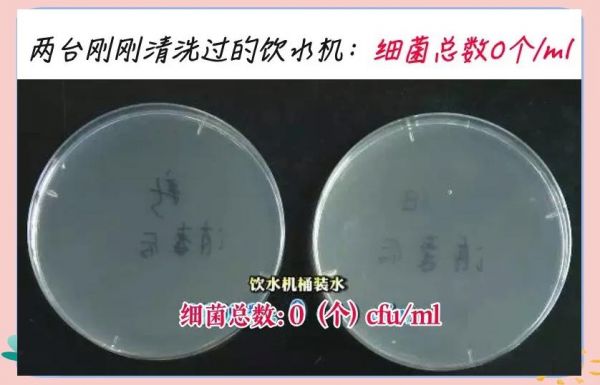

如何保持健康的饮水习惯与安全
01推荐的饮水量
每天应该摄取多少水才健康呢?专家推荐饮水量为1500至1700毫升。这一建议基于《中国居民膳食指南(2022)》的推荐,该指南指出,在温和的气候条件下,成年女性若进行轻体力活动,每日应饮用1500毫升水,而成年男性则需摄入1700毫升。
即使喝得很少,也不一定会立刻感到口渴,但当身体发出缺水信号时,就已经处于缺水状态了。因此,建议大家养成随时补充水分的习惯,不要等到口渴才喝水。每次喝水时,适量饮用200~300ml为宜。

◇ 高血压患者的饮水注意
对于患有高血压合并肾功障碍或高血压合并心衰并发症的患者,应在医生的指导下合理饮水。同时,也要注意,虽然水是生命之源,但并非越多越好。
◇ 过高或过低饮水风险
过多摄入水分可能给肾脏带来额外负担,甚至引发水中毒等风险。水中毒,一个不常被提及却值得关注的话题。当我们的身体摄入过多的水分,超过了肾脏的排泄能力时,就可能引发水中毒。这种状况虽然不常见,但了解其背后的机制和风险,能帮助我们更好地保持水分平衡,避免不必要的健康风险。
02最佳饮水的温度和含糖饮料替代
◇ 适宜的饮水温度
喝水的最佳水温范围在10~40℃。根据《中国居民膳食指南(2022)》的建议,适宜饮用的水温应在这个范围内,类似于凉白开的温度。避免饮用温度过高或过低的饮品。刚出锅的汤和刚泡好的咖啡、茶饮,温度通常在80~95℃,不宜直接饮用。世界卫生组织及国际癌症机构均提醒,饮用超过65℃的热饮可能烫伤食管黏膜,增加患食管癌的风险。同时,过量饮用冰水等温度过低的水会导致肠胃血管突然收缩,减少肠胃血液供应,可能引发胃痉挛、腹痛和腹泻等不适。
◇ 含糖饮料的风险与替代方案
含糖饮料以水和添加糖为主要成分,其营养价值和营养素密度相对较低。过量饮用含糖饮料可能增加患龋齿、超重肥胖、2型糖尿病以及血脂异常的风险。因此,推荐以白水或淡茶水来替代含糖饮料,以确保健康饮水。
对于那些,尤其是儿童,不太喜欢饮用无味水的情况,我们可以尝试在水中加入1至2片新鲜的柠檬片或3至4片薄荷叶,这样不仅能增添水的色彩,还能改善其口感。此外,自制一些传统的饮品,例如绿豆汤或酸梅汤,同样是一种不错的选择,但请注意,在制作过程中不要额外添加糖分。

03饮水中的矿物质与桶装水安全
◇ 矿物质的重要性
纯净水,即不含杂质或细菌的水,是以达到生活饮用水卫生标准的水为原料,经过离子交换、反渗透等工艺处理,有效去除了水中的有害物质。然而,这一过程也导致了对人体有益的矿物质和微量元素被一并去除。因此,长期仅饮用纯净水并不利于人体健康。
无论我们的饮食结构多么丰富,饮水都是人体摄取矿物元素的重要途径之一。尽管纯净水在安全性方面表现优异,但如果人们长期仅饮用纯净水,特别是那些膳食中矿物质摄入不足的人群,将面临一系列潜在健康风险。研究显示,纯净水中钙、镁等矿物质含量相对较低,长期饮用这样的水可能会提升心血管疾病的风险,并对骨骼健康产生不利影响。

◇ 桶装水质量与选购要点
尽管桶(瓶)装水在市场上被广泛认为比自来水更为干净和安全,但事实并非总是如此。近期,我国某地质量监督部门对204批次桶(瓶)装饮用水产品进行了抽检,结果显示不合格率高达14.22%。这表明,桶(瓶)装水的质量并非仅取决于生产环节,而是与水源、水桶(瓶)以及使用过程中的每一个环节都息息相关,任何环节的疏忽都可能导致污染。

因此,在挑选和使用桶(瓶)装饮用水时,我们需留心以下几个要点:
①优选那些标注有质量安全认证、在市场上享有一定知名度的桶(瓶)装饮用水,并避免购买无证产品。
②即便是质量上乘的桶(瓶)装饮用水,在开封后若放置时间过久也容易滋生细菌。因此,建议大家尽量在最短的时间内饮用完毕。对于人数较少的家庭,可以选择容量较小的桶(瓶)装水,从而缩短饮用时间,确保安全与卫生。
③若使用饮水机来搭配桶装水,务必注意对饮水机内胆进行彻底清洗。
相关知识
如何保持健康的饮食习惯
如何正确饮水保持水分平衡?你的饮水习惯健康吗?
如何保持健康的饮食和作息习惯?
什么是健康的饮食习惯,如何保持?
孕妇如何保持健康的饮食选择与习惯?
如何保持健康的饮食习惯?
孕妇生活习惯:如何保持良好的作息与运动习惯
健康饮食指南:如何保持健康的饮食习惯?
健康生活:如何保持健康的饮食习惯?
饮食健康与节日,如何在节日中,保持健康饮食习惯?
网址: 如何保持健康的饮水习惯与安全 https://www.trfsz.com/newsview1318735.html
推荐资讯
- 1发朋友圈对老公彻底失望的心情 12775
- 2BMI体重指数计算公式是什么 11235
- 3补肾吃什么 补肾最佳食物推荐 11199
- 4性生活姿势有哪些 盘点夫妻性 10428
- 5BMI正常值范围一般是多少? 10137
- 6在线基础代谢率(BMR)计算 9652
- 7一边做饭一边躁狂怎么办 9138
- 8从出汗看健康 出汗透露你的健 9063
- 9早上怎么喝水最健康? 8613
- 10五大原因危害女性健康 如何保 7828
